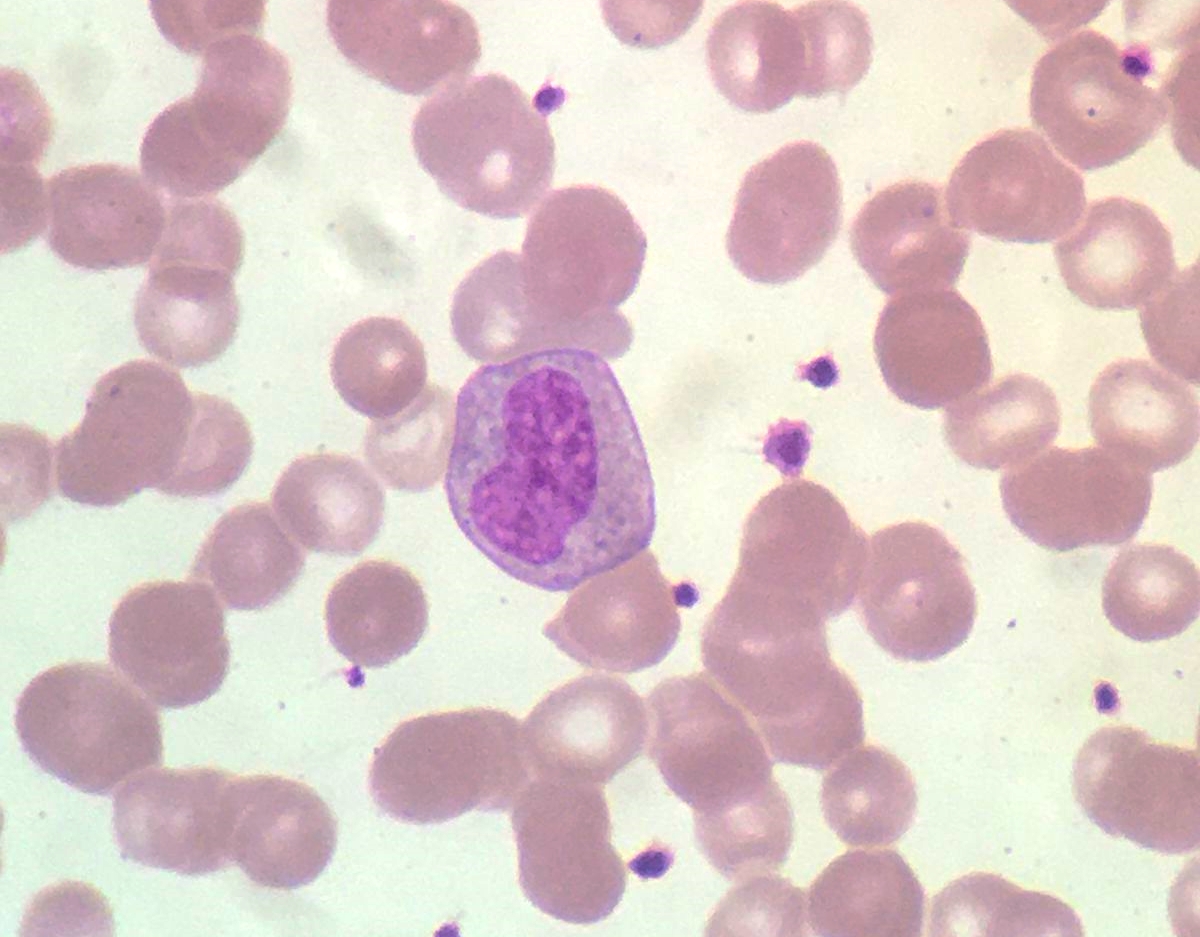
Fully committed and acquiring functionality! 6 days to open the abstract submission platform. #WeLoveNeutrophils

Neutrophil2021
@neutrophil2021
Official twitter account for The Neutrophil International Symposium “Zoomed In”. Follow for meeting updates. #Neutrophil2021
ID: 1031434702392094720
http://theneutrophil.com/ 20-08-2018 06:56:10
244 Tweet
415 Followers
99 Following

Neutrophil2021 Which phospho serine residues do you consider are enough to activated NADPH-OXIDASE complex?

Call now open for Journal of Leukocyte Biology #Neutrophil2021 Proceedings Special Issue. See website for dates & more info theneutrophil.com/proceedings/ Society for Leukocyte Biology



Breaking news! Next #Neutrophil meeting will be in Mexico City 🇲🇽 Follow Neutrophil2022 for more details ⬇️⬇️⬇️

If you love #neutrophils you definitely want to follow Neutrophil2022 for updates on the next international #neutrophil meeting in Mexico City ⬇️



Dr. Arturo Zychlinsky (MPI Berlin) will impart the keynote lecture at Neutrophil 2022. Title: Neutrophil chromatin and immune defense. Arturo Zychlinsky

Follow Neutrophil2022 ⬇️ for more details on the next #neutrophil symposium in #mexico



Abstract submission for #Neutrophil2022 now open ⬇️ follow Neutrophil2022



4 DAYS to close the early bird registration to the Neutrophil 22 International Symposium! Spread the word! CDMX December 3-6, 2022 #WeLoveNeutrophils #Neutrophils Sociedad Mexicana de Inmunología (SMI) Journal of Leukocyte Biology Society for Leukocyte Biology The Histochemical Society Tecnológico de Monterrey Conexión Cinvestav Saber_IMSS UNAM